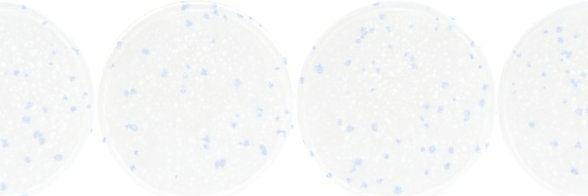
UF IDDynamics banner

UF IDDynamics retweetledi

Responding more effectively to public health emergencies.
Two @UF & @UF_EPI faculty are part of a new CDC-funded outbreak analytics and disease modeling network, designed to improve our nation's response to the outbreak of infectious diseases. phhp.ufl.edu/2023/09/28/uf-…
English